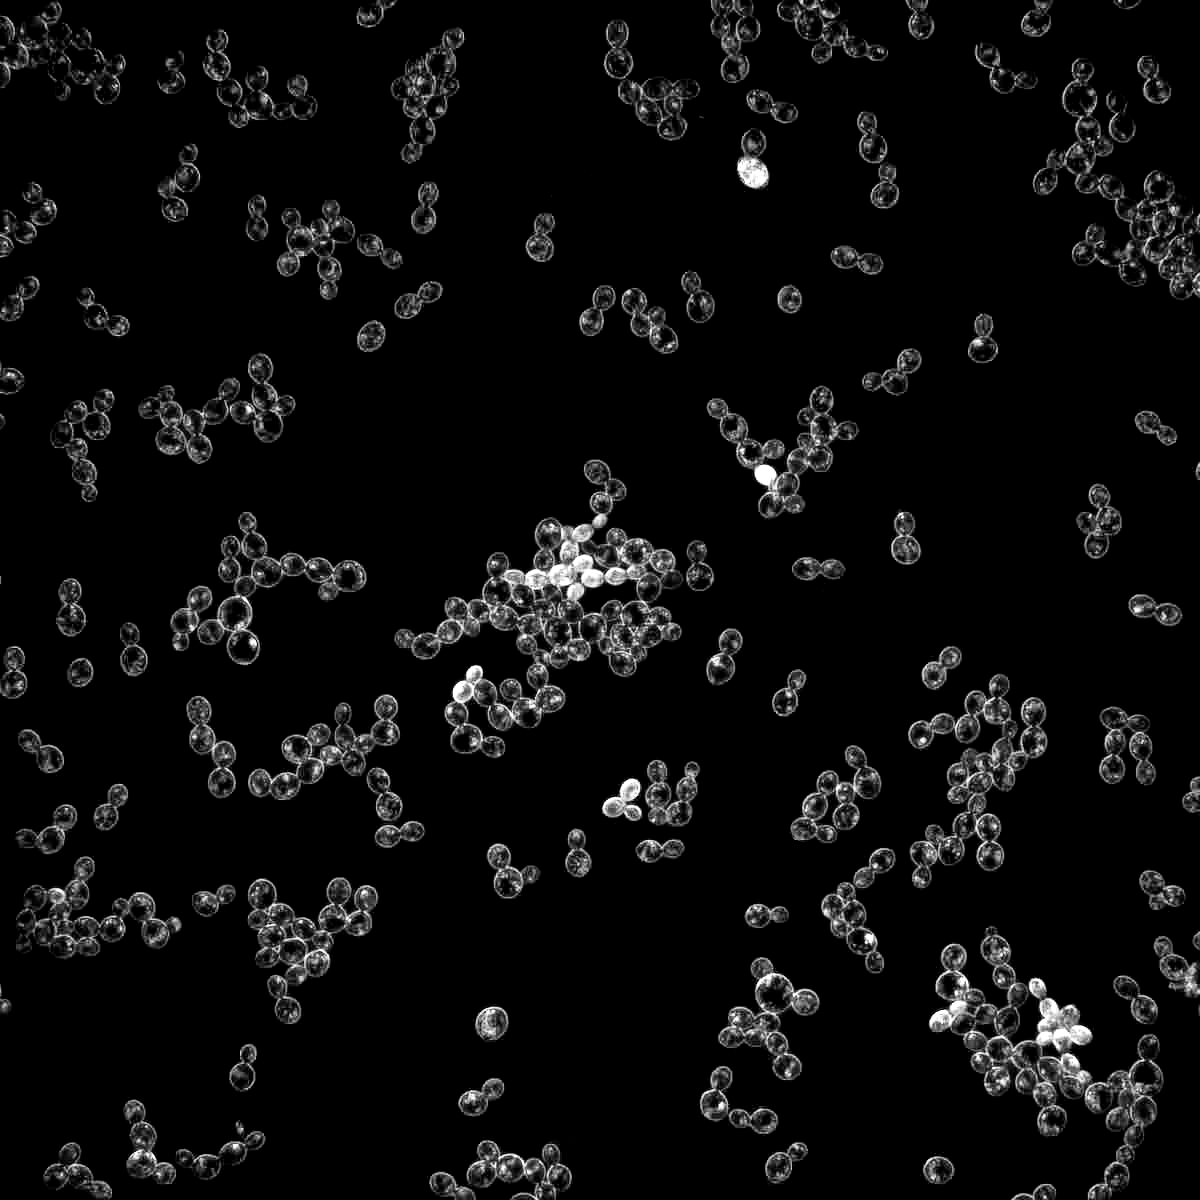
1275

Strain: 1275
Thames Valley Ale
Species: Saccharomyces cerevisiae
Profile: This strain produces classic British bitters with a rich, complex flavor profile. The yeast has a light malt character, low fruitiness, low esters and is clean and well balanced.
Used in:
-
Flocculation
Low Medium -
Apparent Attenuation
77% -
Apparent ABV Tolerance
10% -
Temperature Range
62-72°F (17-22°C)